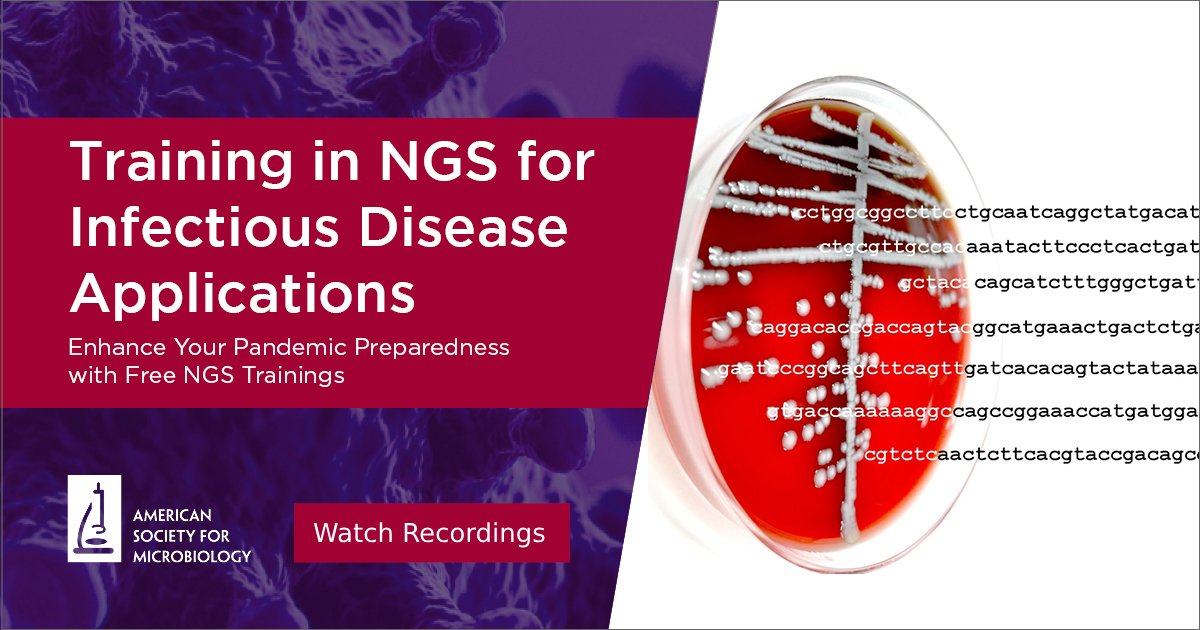
ASM is pleased to announce that the #ASMClinMicro webinar series "NGS for Infectious Disease Applications" is now available for on-demand viewing. No ASM membership needed. Enjoy this content now &amp; be sure to share w/ your colleagues! Watch the recordings: asm.social/1vq

Qian Lin Lee
@qianlinlee1343
DPhil student @TangLabOxford @Dunn_School @UniofOxford
ID: 1647869160528007169
17-04-2023 07:47:00
40 Tweet
59 Takipçi
106 Takip Edilen



Want know which gonococci have which b-lactamase plasmid? Here's how to find out! Well done Tabea Elsener Ana Cehovin Maiden Lab!! 👏🍾 Why those interesting links with AMR genes, other plasmids and lineages? Answers soon 🤞 microbiologyresearch.org/content/journa…

Super proud of this! The first milestone of my PhD published in Microbiology Society Microbial Genomics 🥳🥳

V proud of Harri getting a PhD place at leading CNS lab. He will be missed for our SerumInstituteIndia vaccine but we are happy for his success/future. We❤️unusual career paths! Special thanks Lindsay and Rachel for advice/support! ucl.ac.uk/ioo/van-der-sp…


Happy day for Samantha McKeand at her Uni of Birmingham Graduation!! With proud supervisor A Rossiter, her son, and Prof Jeff Cole IMIBirmingham. Well done everyone! 👏🍾





Interested in gonococcal #plasmids? Come and find me at poster B16 at today's poster session at 23rd International Pathogenic Neisseria Conference 🙂



Pathogen exchange! Never thought a Gc AMR plasmid came from N meningitidis. Well done Wearn Xin (Edeline) (in Joe Bondy-Denomy lab) Ana Cehovin Tabea Elsener Maiden Lab! Supporting our societies' journals ASM journals.asm.org/doi/epub/10.11… editor pick


We 💕beta-barrel proteins (see sciencedirect.com/science/articl… and sciencedirect.com/science/articl…) We also 💕beta-barrel cakes with extracellular chocolate loops! 🤣 Many thanks and congratulations Rebekah Jones on your first PorB paper!!



That was fun! I had the pleasure today to present my work on gonococcal plasmids at Microbiology Society conference #Microbio24 Thanks for the stimulating questions and discussions afterwards!


Fab four from the lab from Dunn_School (now @DunnSchool.bsky.social) in Edinburgh for Microbiology Society #Microbio24. Hope that SenTanuka Tabea Elsener @veronikabaku and Phuong OUCRU enjoy presenting your posters and talks!


More pictures from #Microbio24 Microbiology Society SenTanuka Tabea Elsener and Phuong from OUCRU


Have data... will travel!! YuGeng Zhang presenting in Boston at the Immune System conference with Wearn Xin (Edeline) now doing her postdoc Joe Bondy-Denomy. Dunn_School (now @DunnSchool.bsky.social) Dunn School GSA reunion on the other side of the Atlantic 😊


OxBacNet: >140 people enjoying science! Great ext. speakers @katcoyte from Evolution, Infection and Genomics (EIG) UoM Foster Lab from Molecular Microbiology Sheffield +those from Dunn_School (now @DunnSchool.bsky.social) Department of Physics at University of Oxford Department of Biochemistry at Oxford University Nuffield Department of Medicine Oxford Population Health (OxPop) Oxford Biology Ineos Oxford Institute for Antimicrobial Research Bringing Micro together!!


Tabea Elsener Dunn_School (now @DunnSchool.bsky.social) Dunn School GSA shortlisted from all student talks at this year's Microbiology Society conference. Gave great talk today, and got 2nd prize overall (1st for bacteria) 😁🤣Many congratulations Tabea!! Another paper coming soon 🤞!!